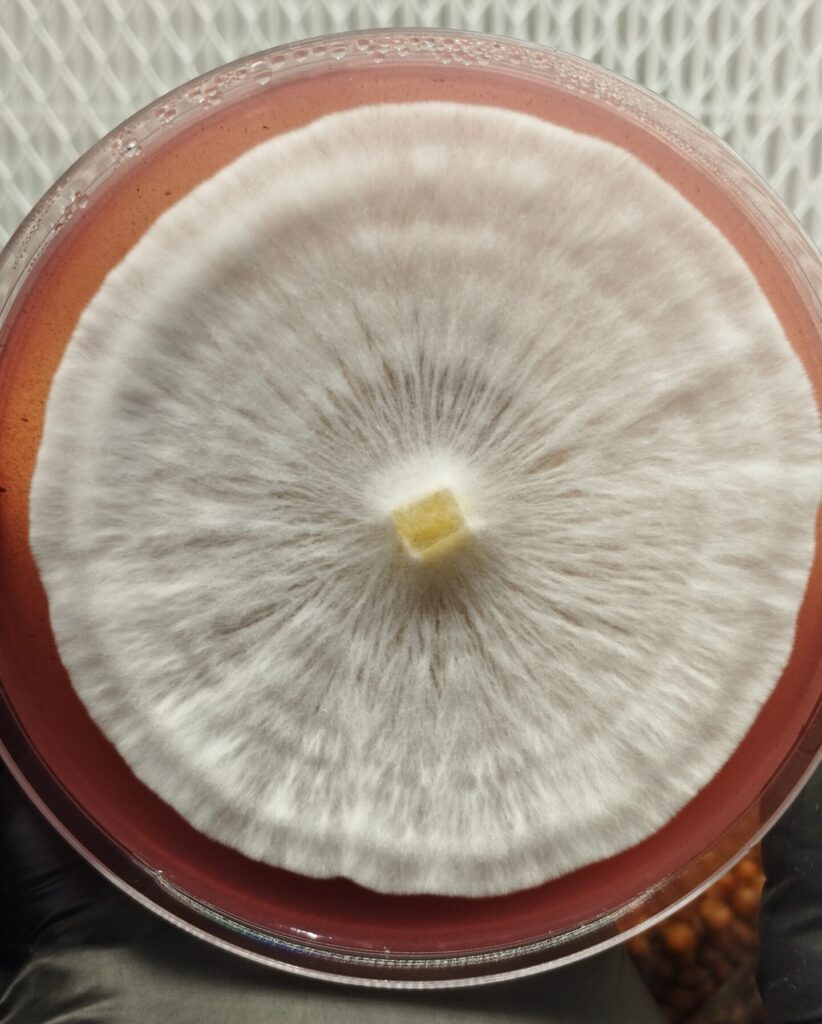

Micología, Cultivo y Biotecnología Con Hongos. Desarrollo y preservación de material genético de setas de alta calidad para estudio, colección e investigación.
- Descubre una selección de esporas y micelio premium, incluyendo las variedades más icónicas:
BIENVENIDO A HIFATEC LAB
En Hifatec Lab trabajamos con Biotecnología aplicada al cultivo de hongos, ofreciendo materiales seleccionados bajo procesos limpios, controlados y responsables. Nuestro enfoque combina investigación calidad y acompañamiento cercano para Coleccionistas e Investigadores que buscan resultados confiables y consistentes.
PRESENTAMOS LA NUEVA BOLSA MASTER ¨Ready-to-Grow¨ ( 3.5L)
Hemos mejorado nuestro sistema para que cultivar en casa sea lo más sencillo posible. Pasamos de los kits pequeños a una Bolsa de 3.5 Litros diseñada para que tú solo te encargues de verlos crecer y cosechar.
¿Qué hace especial a este nuevo sistema?
Tú no tienes que armar nada: Nosotros ya hicimos la parte difícil. La bolsa te llega ya inoculada con el grano y el sustrato en marcha. Es un sistema listo para que el hongo empiece a trabajar desde el primer día.
- Más alimento, mejores resultados: Al ser una bolsa de 3.5 litros (más grande que los botes anteriores), el hongo tiene mucha más fuerza y agua, lo que te da cosechas más abundantes y grandes.
- Se cuida casi sola: La bolsa tiene un doble parche de ventilación especial. Esto permite que el hongo respire aire limpio sin que tú tengas que estar abriendo o atomizando durante el crecimiento. El riesgo de que algo salga mal es mínimo porque la bolsa se mantiene sellada.
¿Cómo funciona? (Así de fácil)
Recibes y acomodas: Pones tu bolsa en un lugar limpio con luz indirecta y buena temperatura.
Solo observa: No necesitas abrirla ni hacerle nada mientras crece.
Ella solita mantiene su humedad.
Cosecha: Solo abres la bolsa cuando ya están listos para recolectar. ¡Es el método más seguro y limpio!
Asesoría personalizada en todo tu proceso por WhatsApp.

El Microcosmos de la Resiliencia Fúngica
¿Por que elegir las genéticas de Hifatec Lab?
En Hifatec Lab, no solo distribuimos micelio; diseñamos el éxito de tu cultivo desde el nivel microscópico. Nuestra misión es acortar la brecha entre el laboratorio de biotecnología y tu estante de fructificación.
Estabilidad Genética Superior
Cada una de nuestras cepas —desde las clásicas hasta nuestras exclusivas han pasado por un riguroso proceso de aislamiento y selección. Trabajamos con linajes probados para garantizar que el vigor que ves en la placa de Petri se traduzca en una colonización rápida y uniforme en el sustrato.
Innovación en el Breeding
Somos especialistas en la creación de variedades únicas. Al cruzar genéticas de alto rendimiento (como nuestras líneas de albino y mutaciones), logramos ejemplares con morfologías excepcionales y una densidad de biomasa que destaca en el mercado. Si buscas algo fuera de lo común, lo encuentras aquí.
Protocolos de Grado Laboratorio
La contaminación es el enemigo número uno. En Hifatec Lab operamos bajo estrictos estándares de esterilidad y control de calidad. Nuestras herramientas y procesos de aislamiento (incluyendo técnicas de mantenimiento como Castellani) aseguran que recibas un material biológico puro, joven y con una vitalidad metabólica al 100%.
Rendimiento Optimizado
Rendimiento Optimizado Nuestras genéticas están seleccionadas para maximizar el "Biological Efficiency" (BE). Esto significa que están adaptadas para aprovechar al máximo los nutrientes del sustrato, ofreciendo cosechas más abundantes y ciclos de cultivo más eficientes, ideales tanto para el investigador como para el productor a mayor escala.
Soporte de Experto a Experto
Elegir Hifatec es elegir un aliado. No solo te llevas una genética; te llevas el respaldo de un equipo apasionado por la micología aplicada y listo para asesorarte en la transición de tus kits de cultivo a proyectos de mayor volumen

¿Necesitas asesoría personalizada?
Estamos listos para ayudarte a elegir el mejor producto para tu proyecto.
Contáctanos hoy mismo.





